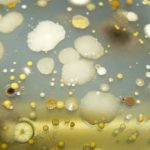

Colombia exporta una media de 120.000 cajas de banana por semana a la zona comunitaria, publica Minuto30.com. El sector de la banana se ha desarrollado de forma considerable en Colombia gracias a la actividad tanto directa como indirecta que ha generado este sector, por lo que se ha convertido en una importante actividad económica en el país.

2017
|
UE consume el 73 por ciento de la banana colombiana
La Unión Europea se ha convertido en el principal socio comercial de Colombia en las exportaciones de banana.